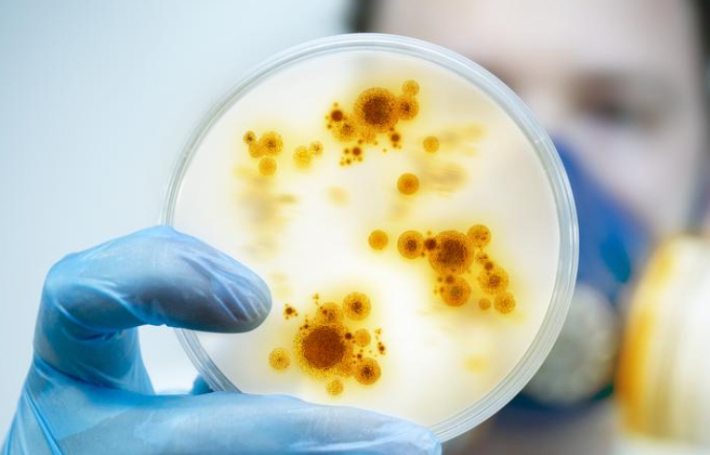
Las infecciones por superbacterias en hospitales ya matan tres veces más que los accidentes de tráfico

Las infecciones por superbacterias en hospitales ya matan tres veces más que los accidentes de tráfico
En el panorama sanitario actual, la realidad es alarmante: las superbacterias se han convertido en uno de los mayores retos para la medicina moderna. Ya no hablamos de un riesgo lejano, sino de una amenaza tangible que cobra más víctimas que los accidentes de tráfico. En España, más de 5.500 personas fallecen cada año en hospitales debido a infecciones causadas por bacterias resistentes, lo que representa un incremento devastador y una alerta clara para todos los profesionales de la salud.
El origen de esta situación radica en el uso indiscriminado de antibióticos durante décadas. Medicamentos que en su momento salvaron millones de vidas, hoy se enfrentan a bacterias que han desarrollado mecanismos para esquivarlos, dando lugar a resistencias múltiples. Este fenómeno no solo complica los tratamientos, sino que pone en riesgo incluso enfermedades que antes eran consideradas fácilmente curables.
El papel crítico del mobiliario de acero inoxidable en hospitales
En esta batalla contra las infecciones, cada detalle cuenta, y uno de los elementos más infravalorados es el mobiliario hospitalario. Mesas, carros y superficies de trabajo hechos en acero inoxidable juegan un papel crucial en la prevención de la propagación bacteriana. Este material no solo es fácil de limpiar y desinfectar, sino que reduce significativamente la retención de patógenos en comparación con otros materiales. Por ello, contar con mesas acero inoxidable es una decisión estratégica para cualquier hospital que busque minimizar riesgos y proteger la salud de sus pacientes.
El acero inoxidable es resistente a la corrosión y a la humedad, condiciones que favorecen la proliferación bacteriana. Por ello, se ha convertido en el estándar de oro para quirófanos, laboratorios y áreas de preparación de alimentos hospitalarios. La correcta implementación de este mobiliario garantiza que la limpieza sea más eficiente y que la exposición a infecciones nosocomiales disminuya de forma considerable.
Resistencia a antibióticos: un problema creciente
María Jesús Lamas, responsable de la Agencia Española del Medicamento, alerta que, aunque el consumo de antibióticos en humanos ha disminuido un 14% desde 2014 y un 60% en animales, la amenaza sigue siendo crítica. Las infecciones por bacterias multirresistentes son ya responsables de más muertes que los accidentes de tráfico, y la previsión es que en 2050 podrían convertirse en la principal causa de fallecimientos a nivel mundial.
Los expertos subrayan que la resistencia a los antibióticos no solo se traduce en infecciones más difíciles de tratar, sino en una mayor vulnerabilidad de los pacientes y en un aumento de complicaciones hospitalarias. Por ello, cada medida preventiva es vital. Una de las estrategias más efectivas es la correcta selección de materiales en el entorno hospitalario, donde el acero inoxidable se erige como el protagonista. Invertir en una mesa trabajo acero inoxidable central es un ejemplo de cómo la infraestructura puede marcar la diferencia en la seguridad de pacientes y profesionales.
Vacunación y prevención: la primera línea de defensa
Además de un entorno limpio y seguro, la prevención mediante vacunas es fundamental. La Asociación Española de Vacunología recuerda que una correcta estrategia de vacunación puede reducir hasta un 22% el consumo de antibióticos, limitando así la aparición de resistencias. Las vacunas protegen a los grupos más vulnerables, especialmente a niños menores de 4 años, y contribuyen a un uso más racional de los antibióticos en la población general.
La prescripción diferida es otra herramienta esencial. Esta técnica permite que los padres o cuidadores dispongan de antibióticos solo si los síntomas no mejoran o empeoran, evitando así el uso innecesario de medicamentos que podrían fortalecer la resistencia bacteriana. Es un modelo de actuación que combina seguridad, eficacia y concienciación.
Conciencia y formación de los profesionales sanitarios
El compromiso de médicos, enfermeros y personal auxiliar es crucial. Cada decisión, desde la limpieza diaria hasta la elección del mobiliario hospitalario, impacta directamente en la reducción de riesgos. Las superficies de acero inoxidable no solo facilitan la higiene, sino que, al ser duraderas y resistentes, permiten un mantenimiento constante sin comprometer la seguridad. Este material es, sin duda, un aliado silencioso en la lucha contra las infecciones nosocomiales.
En el contexto hospitalario, la higiene y la prevención no son opcionales. Cada mesa, cada estante y cada superficie de trabajo deben ser considerados como barreras activas frente a las superbacterias. La inversión en muebles de acero inoxidable de alta calidad no es un gasto, sino una estrategia de protección que salva vidas. La evidencia científica respalda esta elección y subraya su importancia en entornos críticos.
Innovación y futuro del mobiliario hospitalario
La tecnología avanza y con ella las soluciones para reducir infecciones. Los muebles de acero inoxidable ahora incorporan recubrimientos antibacterianos, diseño modular para facilitar la limpieza y superficies que minimizan la acumulación de suciedad. Cada innovación se traduce en menor riesgo de contagio y en una mejora tangible de la seguridad hospitalaria.
Asimismo, la colaboración con proveedores especializados garantiza que los hospitales cuenten con productos certificados, resistentes y adaptables a sus necesidades. La selección de mesas, carros y superficies de trabajo de acero inoxidable no es solo una cuestión estética, sino una decisión estratégica que impacta directamente en la salud pública.
Información y concienciación: mantenernos alerta
Los medios y plataformas especializadas cumplen un papel esencial. Estar informados sobre la evolución de las resistencias, las nuevas normativas y las estrategias de prevención permite a hospitales y profesionales anticiparse a riesgos. Para estar al día, es recomendable seguir noticias relevantes sobre salud pública y control de infecciones.
El conocimiento es poder, y en este caso, poder salvar vidas. Cada artículo, informe o guía sobre resistencias bacterianas contribuye a una cultura de prevención que beneficia a pacientes y profesionales. La combinación de vigilancia, educación y diseño hospitalario basado en acero inoxidable conforma un enfoque integral para combatir la amenaza de las superbacterias.
Acero inoxidable como aliado contra las superbacterias
Por lo tanto, las superbacterias representan una crisis real y creciente en los hospitales, con un impacto superior al de los accidentes de tráfico. La prevención efectiva no se limita al control de antibióticos o vacunación, sino que abarca todos los elementos del entorno hospitalario. El mobiliario de acero inoxidable emerge como una herramienta esencial para reducir riesgos, mejorar la higiene y proteger la salud de pacientes y profesionales.
Invertir en mesas, estanterías y superficies de acero inoxidable es invertir en seguridad, eficiencia y futuro. Cada superficie limpia y desinfectable, cada mesa de trabajo resistente y cada decisión preventiva contribuyen a frenar la propagación de bacterias multirresistentes. En este contexto, la innovación y la concienciación forman la línea más efectiva de defensa frente a un enemigo invisible pero letal.
El desafío es mayúsculo, pero con medidas adecuadas, compromiso profesional y materiales de alta calidad como el acero inoxidable, los hospitales pueden convertirse en espacios más seguros y resilientes frente a las infecciones nosocomiales. La prevención comienza en los detalles: y el detalle del acero inoxidable salva vidas.